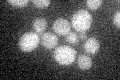
YPL123C
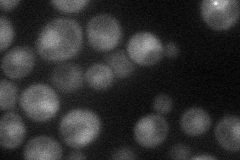
YPL123C
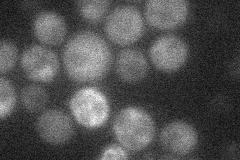
YPL123C
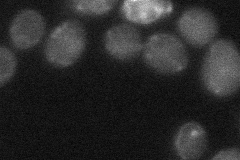
YPL123C
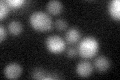
YPL123C
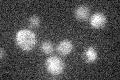
YPL123C

View description
Vacuolar RNase of the T(2) family, relocalizes to the cytosol where it cleaves tRNAs upon oxidative or stationary phase stress; promotes apoptosis under stress conditions and this function is independent of its catalytic activity
Localization:
Intensity:
Fold change:
Significance:
-
C’ GFP library in SD
below threshold15.94 -
N' NOP1pr-GFP in SD
cytosol,punctate37.9096 -
N' TEF2pr-mCherry in SD
cytosol14.9526 -
N' NATIVEpr-GFP in SD

below threshold19.828 -
N' TEF2pr-VC and Cyto-VN in SD
below threshold23.9135 -
C’ GFP library in SD+DTT
cytosol16.051No -
C’ GFP library in SD+H2O2

cytosol17.811.11No -
C’ GFP library in Starvation Media
cytosol13.40.84No -
C’ GFP library on the background of Pup2-DaMP

below threshold -
C’ GFP library on the background of CCT mutant

below threshold17.57251.10181No
